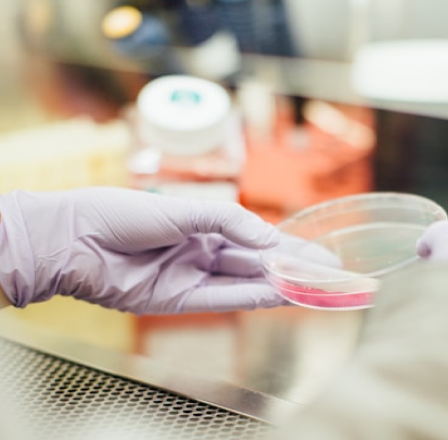

How Leading Enterprises put Nanonets AI to work
WHY BUSINESSES CHOOSE NANONETS
Measurable ROI in weeks
5x
Faster turnaround time
100%
Accuracy at lowest cost
10x
Faster setup than industry standards
Enterprise knowledge is trapped. We turn it into autonomous decisions.

Powerful AI that allows enterprises to automate unstructured document processing at scale

Seamlessly process documents from your input and output accounting stack. Nanonets supports integration with most accounting and ERP software with certified in-built connectors for tools.




Don’t see what you’re looking for? We’ve integrated with 100+ software vendors for complex workflows - we’ll figure out a way for you.
SOC II, GDPR & ISO 27001 Certified. Nanonets is certified for highest grade security certifications



